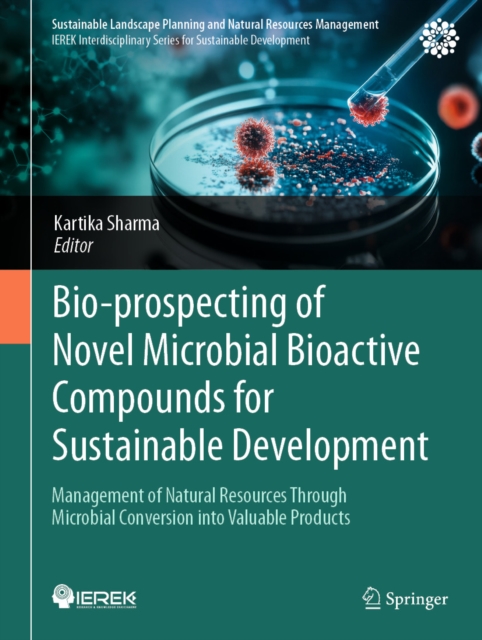

Bio-prospecting of Novel Microbial Bioactive Compounds for Sustainable Development
This book discusses current developments and upcoming trends in the microbial synthesis of various bioactive compounds from waste product which have a very good market worldwide. The extraction of biologically active compounds from microorganisms is still essential for the creation of novel pharmaceuticals and agricultural chemicals, and has underpinned their application as drugs and functional fo...
This book discusses current developments and upcoming trends in the microbial synthesis of various bioactive compounds from waste product which have a very good market worldwide. The extraction of biologically active compounds from microorganisms is still essential for the creation of novel pharmaceuticals and agricultural chemicals, and has underpinned their application as drugs and functional fo...